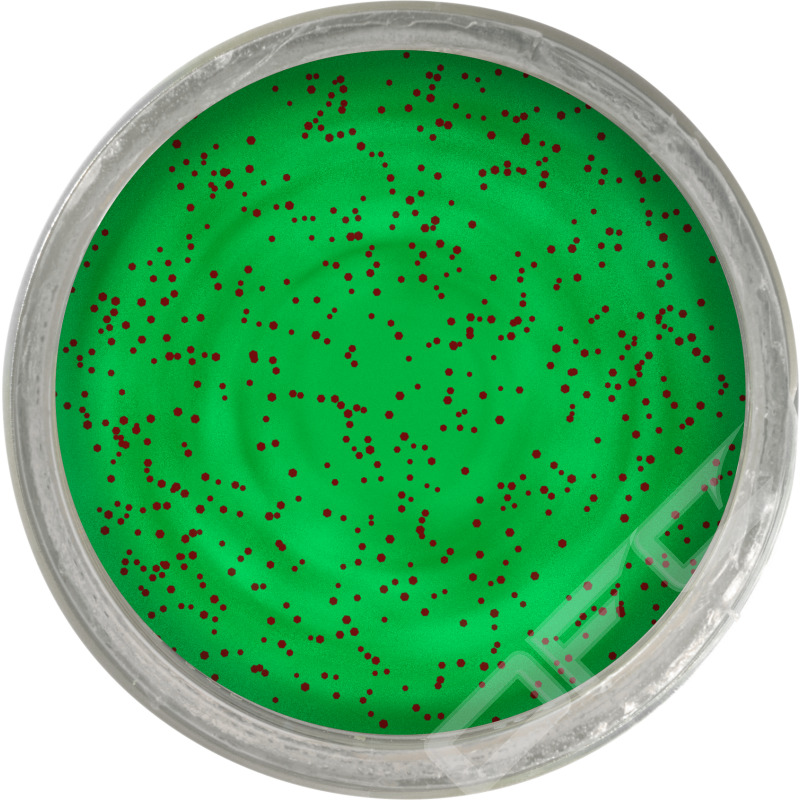

Berkley PowerBait Trout Dough Fruits Apple Jack
PowerBait Trout Dough Fruits-serien är en samling fruktdoftande Powerbait och de har färger som matchar det finaste naturen har att erbjuda. Alla med beprövad PowerBait-formel och attraktivt glitter!
• Boostad med mycket glitter
• Beprövad PowerBait-formel
• Perfekt formbar
• Ingen öring kan motstå denna färg- och doftkombination
71,20 kr (89 kr)
Vårt lägsta pris 1-30 dagar innan prissänkning: 89 kr
| Artikel | 357510 |
| Brand: | Berkley |
| Color: | Apple Jack |